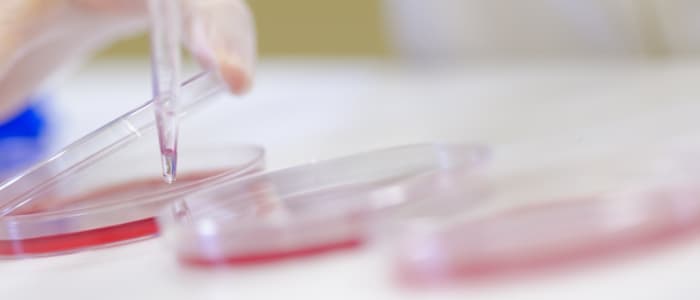
Investigamos sin pausa para que el campo de la reproducción animal continúe avanzando

Especialistas en tecnologías veterinarias y de la reproducción
Juntos desde 1996
Más de 30 años de experiencia
Nuestras líneas de producto
Encuentra la solución que necesitas de forma ágil y sencilla

Análisis y Laboratorio
Analizamos la calidad seminal y mucho más en nuestro propio laboratorio biotecnológico
Conocer el servicio
Auditoría y asesoría
Estudiamos la situación de tu granja o centro de inseminación y te ayudamos a mejorar
Conocer el servicio
Investigación
Investigamos sin pausa para que el campo de la reproducción animal continúe avanzando
Conocer el servicioDescubre nuestros software, desarrollados para mejorar y facilitar el trabajo del sector veterinario y ganadero

Software
Ecotext
Analíza la ecotextura testicular a través de imágenes ecográficas para determinar la calidad del reproductor, así como las posibles anomalías espermáticas.

Software
MeatQtext
Permite medir de manera objetiva la infiltración grasa del lomo, la grasa subcutánea, el área de ojo de lomo y la profundidad de músculo.


Calidad certificada y homologada
Nuestros productos, investigaciones y servicios están avalados por las instituciones más relevantes del sector.




Últimas noticias sobre Humeco y el sector de la reproducción animal
Ver todoColaboramos con:




